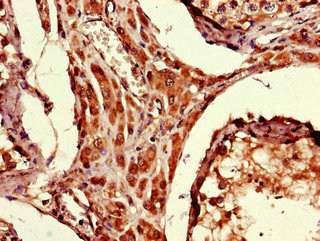
ARRDC1-AS1 Antibody in Immunohistochemistry (Paraffin) (IHC (P))

Search
Invitrogen
ARRDC1-AS1 Polyclonal Antibody
{{$productOrderCtrl.translations['antibody.pdp.commerceCard.promotion.promotions']}}
{{$productOrderCtrl.translations['antibody.pdp.commerceCard.promotion.viewpromo']}}
{{$productOrderCtrl.translations['antibody.pdp.commerceCard.promotion.promocode']}}: {{promo.promoCode}} {{promo.promoTitle}} {{promo.promoDescription}}. {{$productOrderCtrl.translations['antibody.pdp.commerceCard.promotion.learnmore']}}

Please note: We are reviewing Western blot images included in the antibody testing data in our catalog, including those provided by third parties. Unless expressly labeled or annotated as “raw-unedited”, Western blot images included in the antibody testing data in our catalog may have been edited, optimized or otherwise adjusted for presentation.
产品信息
PA5-144189
种属反应
宿主/亚型
分类
类型
抗原
偶联物
形式
浓度
规格
纯化类型
保存液
内含物
保存条件
运输条件
RRID
靶标信息
ARRDC1-AS1 is a gene that is also known as Arrestin Domain Containing 1 Antisense RNA 1. It is categorized as an antisense RNA, which is a type of RNA molecule that is transcribed from the opposite strand of a protein-coding gene. ARRDC1-AS1 is specifically transcribed from the antisense strand of the ARRDC1 gene.The specific function of ARRDC1-AS1 is not yet fully understood, and further research is required to elucidate its role in cellular processes and its potential implications for human health and disease. Antisense RNAs have been found to play important regulatory roles in gene expression, including the regulation of transcription, mRNA stability, and translation. Therefore, understanding the specific functions and mechanisms of ARRDC1-AS1 may provide valuable insights into the molecular processes underlying gene regulation.
仅用于科研。不用于诊断过程。未经明确授权不得转售。
篇参考文献 (0)
生物信息学
蛋白别名: C9orf37
Entrez Gene ID: (Human) 85026